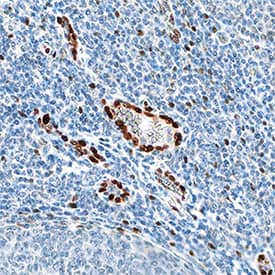
IL-33 antibody in Human Tonsil by Immunohistochemistry (IHC-P).

Human IL-33 Antibody
R&D Systems, part of Bio-Techne | Catalog # MAB36253


Key Product Details
Species Reactivity
Validated:
Cited:
Applications
Validated:
Cited:
Label
Antibody Source
Product Specifications
Immunogen
Ser112-Thr270
Accession # O95760
Specificity
Clonality
Host
Isotype
Scientific Data Images for Human IL-33 Antibody
Detection of Human IL‑33 by Western Blot.
Western blot shows lysates of HEK293 human embryonic kidney cell line either mock transfected or transfected with human IL-33. PVDF membrane was probed with 1 µg/mL of Goat Anti-Human IL-33 Monoclonal Antibody (Catalog # MAB36253) followed by HRP-conjugated Anti-Goat IgG Secondary Antibody (HAF017). A specific band was detected for IL-33 at approximately 30 kDa (as indicated). This experiment was conducted under reducing conditions and using Immunoblot Buffer Group 1.IL‑33 in Human Tonsil.
IL-33 was detected in immersion fixed paraffin-embedded sections of human tonsil using Goat Anti-Human IL-33 Monoclonal Antibody (Catalog # MAB36253) at 0.1 µg/mL overnight at 4 °C. Tissue was stained using the Anti-Goat HRP-DAB Cell & Tissue Staining Kit (brown; CTS008) and counterstained with hematoxylin (blue). Specific staining was localized to nuclei in epithelial cells. View our protocol for Chromogenic IHC Staining of Paraffin-embedded Tissue Sections.Detection of IL-33 in Human Peripheral Blood Lymphocytes by Flow Cytometry.
Human peripheral blood lymphocytes were stained with (A) Goat Anti-Human IL-33 Monoclonal Antibody (Catalog # MAB36253) or (B) Goat IgG control antibody (Catalog # AB-108-C) followed by anti-Goat IgG PE-conjugated secondary antibody (F0107) and Mouse anti-Human CD19 APC-conjugated Monoclonal Antibody (FAB4867A). To facilitate intracellular staining, cells were fixed with Flow Cytometry Fixation Buffer (FC004) and permeabilized with methanol. View our protocol for Staining Intracellular Molecules.Applications for Human IL-33 Antibody
Immunohistochemistry
Sample: Immersion fixed paraffin-embedded sections of human tonsil
Intracellular Staining by Flow Cytometry
Sample: Human PBMCs or HUVECs fixed with Flow Cytometry Fixation Buffer (Catalog # FC004) and permeabilized with ice-cold methanol
Western Blot
Sample: HEK293 human embryonic kidney cell line transfected with human IL-33
Human IL-33 Sandwich Immunoassay
Formulation, Preparation, and Storage
Purification
Reconstitution
Formulation
Shipping
Stability & Storage
- 12 months from date of receipt, -20 to -70 °C as supplied.
- 1 month, 2 to 8 °C under sterile conditions after reconstitution.
- 6 months, -20 to -70 °C under sterile conditions after reconstitution.
Background: IL-33
IL-33, also known as NF-HEV and DVS 27, is a 30 kDa proinflammatory protein that may also regulate gene transcription (1‑3). DVS 27 was identifed as a gene that is up‑regulated in vasospastic cerebral arteries (1). NF-HEV was described as a nuclear factor that is preferentially expressed in the endothelial cells of high endothelial venules relative to endothelial cells from other tissues (2). IL-33 was identified based on sequence and structural homology with IL-1 family cytokines (3). DVS 27, NF-HEV, and IL-33 share 100% amino acid sequence identity. IL-33 is constitutively expressed in smooth muscle and airway epithelia. It is up‑regulated in arterial smooth muscle, dermal fibroblasts, and keratinocytes following IL-1 alpha or IL-1 beta stimulation (1, 3). Similar to IL-1, IL-33 can be cleaved in vitro by caspase-1, generating an N-terminal fragment that is slightly shorter than the C-terminal fragment (3, 4). The N-terminal portion of full length IL-33 contains a predicted bipartite nuclear localization sequence and a homeodomain-like helix-turn-helix DNA binding domain. By immunofluorescence, full length IL-33 localizes to the nucleus in HUVECs and transfectants (2). The C-terminal fragment, corresponding to mature IL-33, binds and triggers signaling through mast cell IL-1 R4/ST2L, a longtime orphan receptor involved in the augmentation of Th2 cell responses (3, 5-7). A ternary signaling complex is formed by the subsequent association of IL-33 and ST2L with IL-1R AcP (8). Stimulation of Th2 polarized lymphocytes with mature IL-33 in vitro induces IL-5 and IL-13 secretion (3). In vivo administration of mature IL-33 promotes increased production of IL-5, IL-13, IgE, and IgA, as well as splenomegaly and inflammatory infiltration of mucosal tissues (3). Full length and mature human IL-33 share 52‑58% aa sequence identity with mouse and rat IL-33. Human IL-33 shares less than 20% aa sequence identity with other IL-1 family proteins.
References
- Onda, H. et al. (1999) J. Cereb. Blood Flow Metab. 19:1279.
- Baekkevold, E.S. et al. (2003) Am. J. Pathol. 163:69.
- Schmitz, J. et al. (2005) Immunity 23:479.
- Black, R.A. et al. (1989) J. Biol. Chem. 264:5323.
- Xu, D. et al. (1998) J. Exp. Med. 187:787.
- Lohning, M. et al. (1998) Proc. Natl. Acad. Sci. USA 95:6930.
- Dinarello, C.A. (2005) Immunity 23:461.
- Chackerian, A.A. et al. (2007) J. Immunol. 179:2551.
Long Name
Alternate Names
Gene Symbol
UniProt
Additional IL-33 Products
Product Documents for Human IL-33 Antibody
Product Specific Notices for Human IL-33 Antibody
For research use only